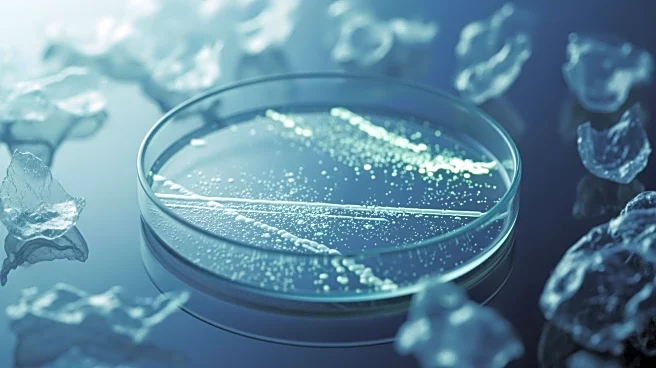
Plastic-Eating Bacteria Offer Potential Solution to Marine Pollution

What's Happening?
Recent data from Similarweb indicates that Google's AI chatbot, Gemini, has significantly increased its market presence, now accounting for 12.9% of total web traffic to online generative AI tools. This marks a substantial rise from 6.4% in 2024. In contrast,
ChatGPT, while still leading the market, has seen its share decrease from 87% to 74% over the same period. The data suggests a shift in the competitive landscape as more AI chatbots enter the market, with companies like Google and Anthropic expanding their offerings. Users have noted Gemini's strengths in routine tasks and its seamless integration with Google's suite of apps, which enhances productivity.
Why It's Important?
The rise of Gemini in the AI chatbot market highlights a growing diversification in the sector, which could lead to increased innovation and competition. This shift may benefit consumers and businesses by providing more options and potentially driving down costs. For Google, the success of Gemini underscores its strategic focus on integrating AI across its services, potentially strengthening its ecosystem and user retention. Conversely, the decline in ChatGPT's market share could prompt OpenAI to innovate further to maintain its leadership position. The broader implications for the AI industry include a potential acceleration in the development of more specialized and integrated AI solutions.
What's Next?
As the competition in the AI chatbot market intensifies, companies are likely to continue enhancing their offerings to capture more market share. Google may further integrate Gemini with its other services, while OpenAI might introduce new features to regain its market dominance. Additionally, other tech developers are expected to follow suit, integrating AI chatbots with popular productivity tools to enhance user experience. The ongoing evolution of AI chatbots will likely lead to more personalized and efficient digital interactions, impacting various sectors, including business, education, and customer service.
Beyond the Headlines
The increasing integration of AI chatbots like Gemini into everyday applications raises important ethical and privacy considerations. As these tools access and utilize personal data to enhance functionality, ensuring robust data protection and user consent will be crucial. Moreover, the reliance on AI for routine tasks could lead to shifts in workforce dynamics, necessitating new skills and roles. The long-term cultural impact of AI chatbots on communication and information processing is also an area for further exploration.